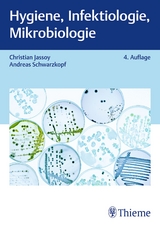
Hygiene, Infektiologie, Mikrobiologie - Schwarzkopf, Andreas; Jassoy, Christian

Hygiene, Infektiologie, Mikrobiologie
Seiten
2018
|
3. aktualisierte Auflage
Thieme (Verlag)
978-3-13-241368-9 (ISBN)
Thieme (Verlag)
978-3-13-241368-9 (ISBN)
- Titel ist leider vergriffen;
keine Neuauflage - Artikel merken
Zu diesem Artikel existiert eine Nachauflage
Infektionskrankheiten verstehen, vermeiden, bekämpfen
Alles was Sie im Bereich Hygiene, Infektiologie und Mikrobiologie wissen müssen. Eignen Sie sich exakt auf die Gesundheitsberufe zugeschnittenes Detailwissen an - sparen Sie sich unnötigen, fachmedizinischen Wissensballast.
Zahlreiche Praxistipps zeigen Ihnen, worauf es bei der Bekämpfung pathogener Mikroorganismen wirklich ankommt. Generalistische Wegweiser ermöglichen ein schnelles Auffinden der wichtigsten Inhalte für die Kinderkrankenpflege und die Altenpflege. Erfahren Sie alles Wesentliche zu neuen Erregern, z.B. Zikavirus, MERS, Ebolavirus, Lassavirus sowie zu, in unseren Gegenden, neuen Überträgern wie der Gelbfiebermücke. Lernen Sie neue Labormethoden, z.B. MALDI-TOF und NAT, Isolationsmaßnahmen sowie neue Standards bei Händehygiene und Handschuhmanagement kennen. 5 Fallbeispiele mit Lösungen unterstützen Sie bei der Selbstkontrolle und Prüfungsvorbereitung.
Ihr nützlicher Begleiter in der Ausbildung, aber auch in der Hygienefachkraftausbildung. Fühlen Sie sich sicher. Schützen Sie sich und Ihre Patienten beim alltäglichen Arbeiten.
Alles was Sie im Bereich Hygiene, Infektiologie und Mikrobiologie wissen müssen. Eignen Sie sich exakt auf die Gesundheitsberufe zugeschnittenes Detailwissen an - sparen Sie sich unnötigen, fachmedizinischen Wissensballast.
Zahlreiche Praxistipps zeigen Ihnen, worauf es bei der Bekämpfung pathogener Mikroorganismen wirklich ankommt. Generalistische Wegweiser ermöglichen ein schnelles Auffinden der wichtigsten Inhalte für die Kinderkrankenpflege und die Altenpflege. Erfahren Sie alles Wesentliche zu neuen Erregern, z.B. Zikavirus, MERS, Ebolavirus, Lassavirus sowie zu, in unseren Gegenden, neuen Überträgern wie der Gelbfiebermücke. Lernen Sie neue Labormethoden, z.B. MALDI-TOF und NAT, Isolationsmaßnahmen sowie neue Standards bei Händehygiene und Handschuhmanagement kennen. 5 Fallbeispiele mit Lösungen unterstützen Sie bei der Selbstkontrolle und Prüfungsvorbereitung.
Ihr nützlicher Begleiter in der Ausbildung, aber auch in der Hygienefachkraftausbildung. Fühlen Sie sich sicher. Schützen Sie sich und Ihre Patienten beim alltäglichen Arbeiten.
| Erscheinungsdatum | 10.07.2018 |
|---|---|
| Zusatzinfo | 220 Abbildungen |
| Verlagsort | Stuttgart |
| Sprache | deutsch |
| Maße | 170 x 240 mm |
| Gewicht | 844 g |
| Einbandart | kartoniert |
| Themenwelt | Medizin / Pharmazie ► Medizinische Fachgebiete ► Mikrobiologie / Infektologie / Reisemedizin |
| Pflege ► Altenpflege ► Ausbildung / Prüfung | |
| Pflege ► Ausbildung / Prüfung ► Anatomie / Physiologie / Biologie | |
| Pflege ► Ausbildung / Prüfung ► Krankheitslehre | |
| Medizin / Pharmazie ► Pflege ► Kinderkrankenpflege | |
| Studium ► 2. Studienabschnitt (Klinik) ► Hygiene / Mikrobiologie / Virologie | |
| Studium ► Querschnittsbereiche ► Infektiologie / Immunologie | |
| Schlagworte | Altenpflege • Arzt • Ausbildung Pflege • Bakteriologie • Corona • Coronavirus • Corona-Virus • Covid 19 • Covid-19 • Ernährungslehre • Ernährungslehre • Gesundheits- und Kinderkrankenpflege • Gesundheits- und Krankenpflege • Homeoffice • Hygiene • Hygienefachkraft • Infektiologie • Infektionen • Infektionskrankheiten • JASSOY • Krankenschwester • KRINKO • Lehrbuch • Mikrobiologie • Pflege • Pflegeausbildung • Pflegeberuf • Pflegeschüler • Pflegeschüler • Prophylaxe • Schwarzkopf • stay home • Virus • Weiterbildung |
| ISBN-10 | 3-13-241368-2 / 3132413682 |
| ISBN-13 | 978-3-13-241368-9 / 9783132413689 |
| Zustand | Neuware |
| Informationen gemäß Produktsicherheitsverordnung (GPSR) | |
| Haben Sie eine Frage zum Produkt? |
Mehr entdecken
aus dem Bereich
aus dem Bereich
für die Generalistische Pflegeausbildung
Buch | Softcover (2023)
Urban & Fischer in Elsevier (Verlag)
CHF 48,95
Lehrbuch für Demenz- und Alltagsbegleitung
Buch | Softcover (2022)
Urban & Fischer in Elsevier (Verlag)
CHF 44,75